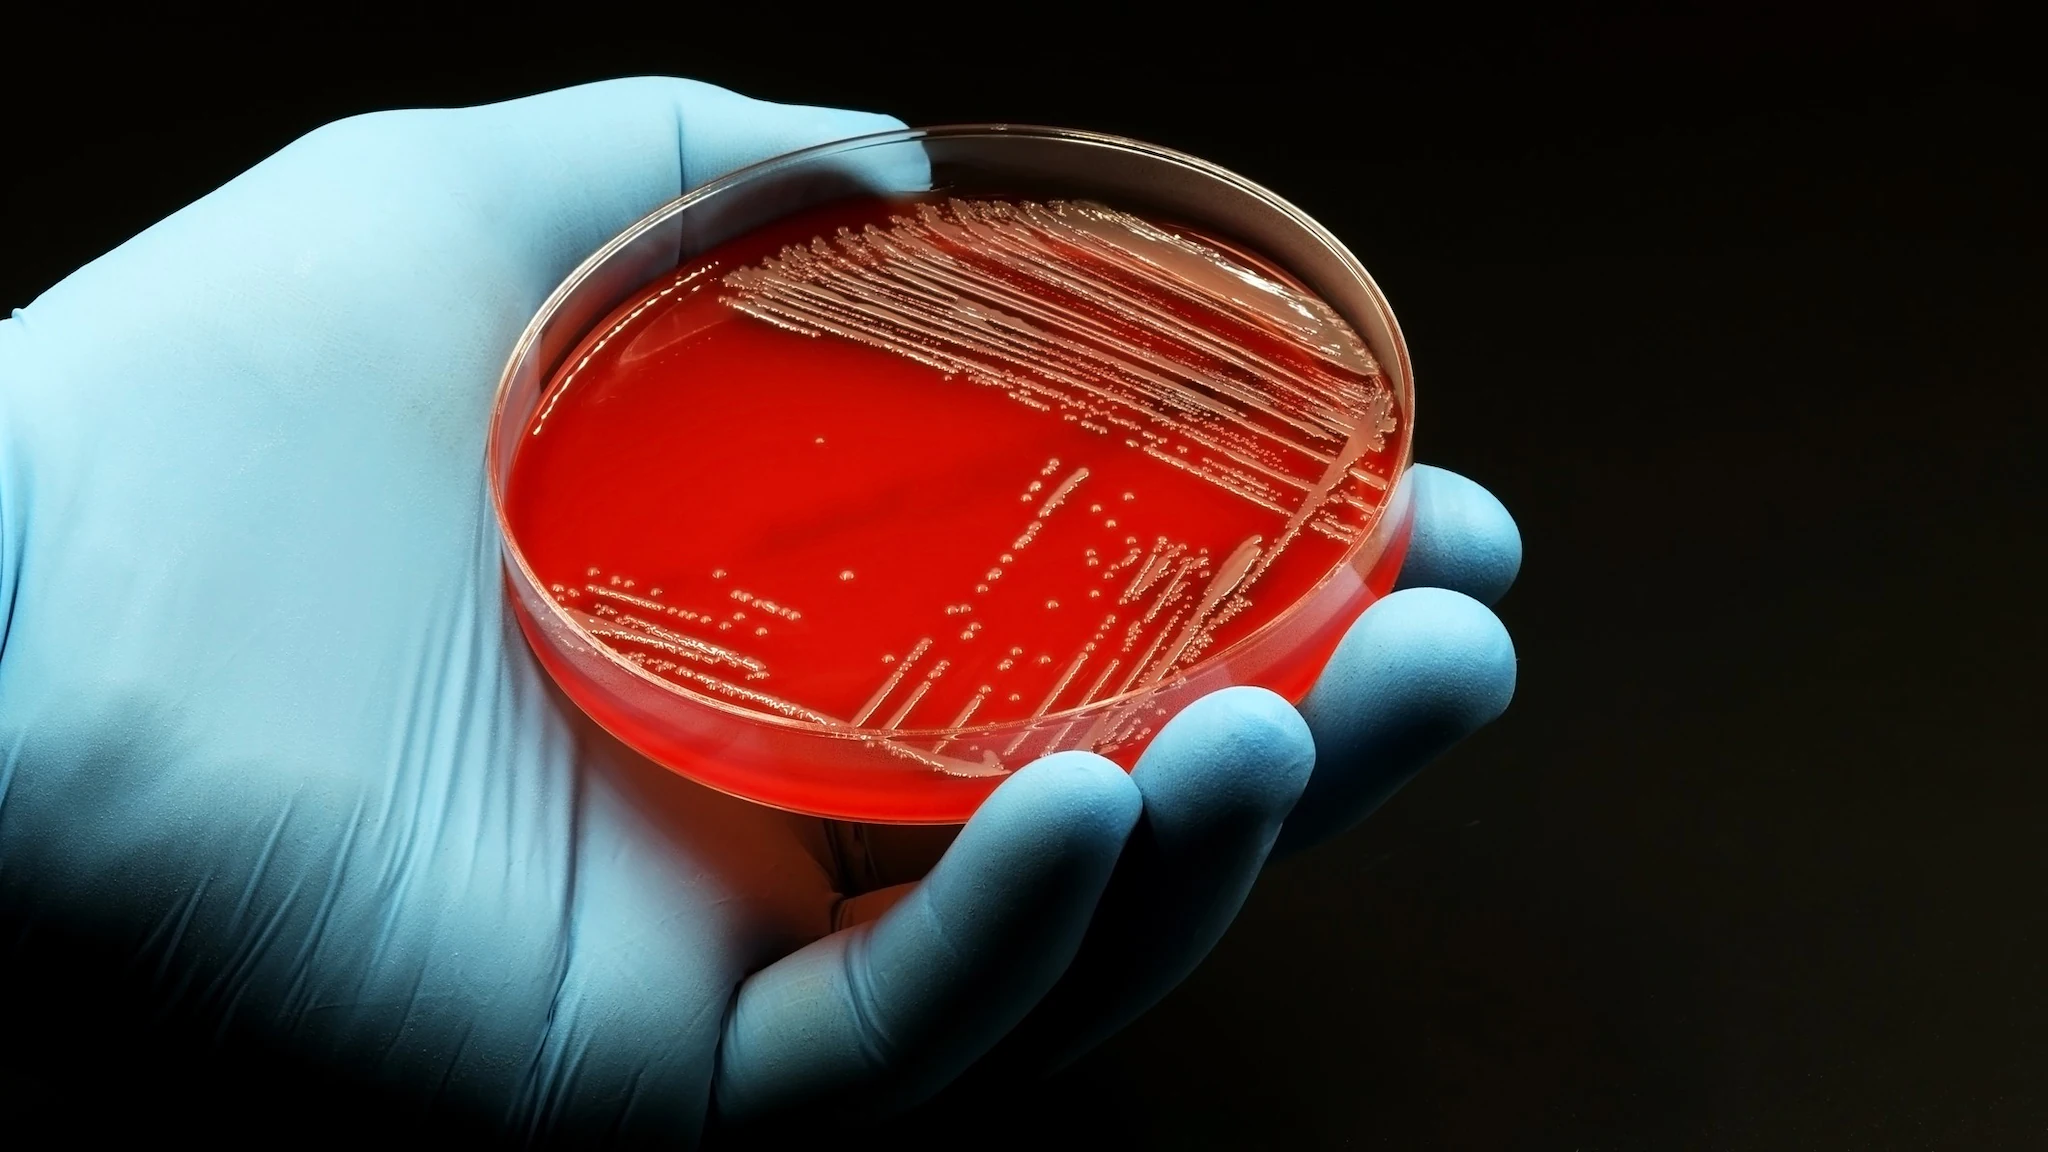
Culture A hand with a blue glove on holding a petri dish with bacteria growing on its red medium inside.

What to know
- Campylobacter infection is diagnosed by a laboratory test.
- Most people recover without using antibiotics.
- Laboratory tests can provide information that your healthcare provider can use to make treatment decisions.
Why get tested
Campylobacter infections can sometimes be serious.
This is especially true for people at risk for severe illness – including people 65 years and older, pregnant people, and people with weakened immune systems.
Types of tests
Campylobacter infection is diagnosed by a laboratory test.
This test could be
- A rapid diagnostic test that detects genetic material of the bacteria, or
- A culture test that grows the bacteria.
Rapid tests allow doctors to quickly determine the cause of a patient’s illness. Culture tests allow doctors to learn more information about the Campylobacter causing infection. This information can help guide treatment decisions.